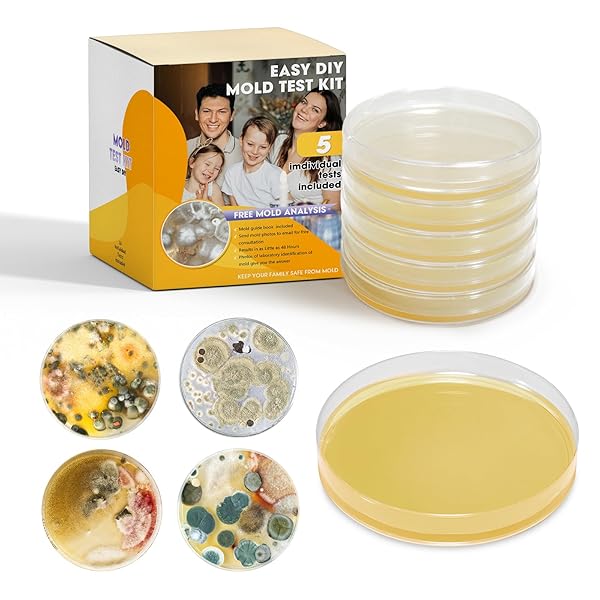
Mold Test Kit for Home with Free Lab Analysis - 5 Simple Detection Tests DIY at Home Mold Air Tester - Test HVAC System,Surface Mold for Home Indoor & Outdoor Air Quality Mold Testing Kits Detector

The name "Amazon" and all its associated trademarks are the sole property of Amazon Inc. We do not claim any ownership or association with the name "Amazon" or its intellectual property. Any mention of the term "Amazon" on this platform is purely for illustrative or informational purposes. We hereby acknowledge Amazon Inc.'s exclusive rights to the name "Amazon" and respect their trademark and intellectual property rights. Product prices and availability are accurate as of the date/time indicated and are subject to change. Any price and availability information displayed on Amazon at the time of purchase will apply to the purchase of the product. Certain content that appears on DealDog comes from Amazon. This content is provided 'as is' and is subject to change or removal at any time. Note: DealDog contains affiliate links, which means we may receive a commission for purchases made through our links at no extra cost for you.